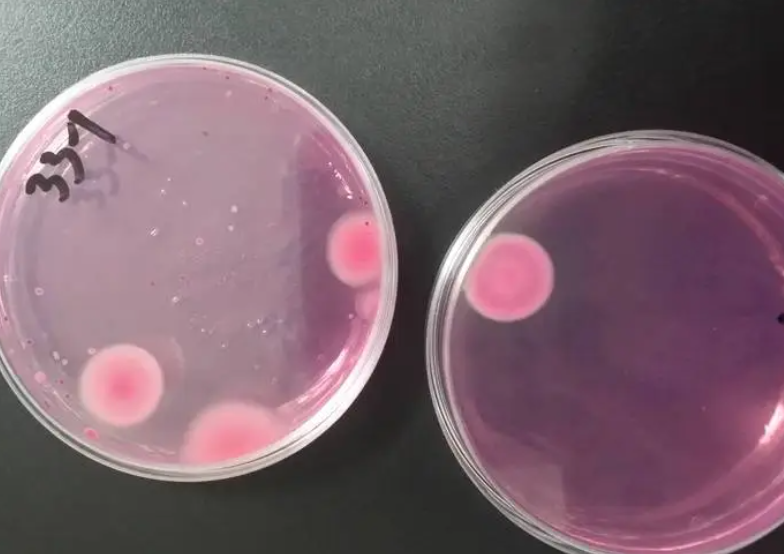

酵母活性检测机构-酵母活性测试中心
类别:其他检测
1137
2025-10-10
1137
2025-10-10
清析技术研究院可提供酵母活性相关的测试检测服务,可出具备CMA/CNAS资质的检测报告,是专业的第三方检测机构。详情可联系我们进行咨询,关于酵母活性检测的部分内容介绍如下:
清析研究院服务范围和优势有哪些?
1、为公司企业、高等院校、科研单位、事业单位、医院、律师事务所以及个人客户等提供专业技术服务。
2、具备专业的CMA/CNAS资质认证,检测资质齐全,为客户提供专业的咨询与服务。
3、实验室仪器设备种类齐全,保证测试数据准确可靠;
4、拥有强大的检测专家团队,全国各地多家分支机构;
5、在线一对一服务流程,根据客户需求制定特色检测方案和解决办法;
酵母活性检测周期是多久?
到样后7-10个工作日可出具检测报告(可加急),根据样品及其检测项目/方法会有所变动,具体需咨询工程师。
酵母活性检测项目有哪些?
酵母活性检测
酵母活性检测范围有哪些?
酿酒酵母、茶酵母、啤酒酵母、面包酵母、饲料酵母、富硒酵母等。
酵母活性检测标准是什么?
1、GB/T 22547-2008 饲料添加剂.饲用活性干酵母(酿酒酵母)
2、QB 2074-1995 酿酒活性干酵母
3、DB61/T 210-2005 活性酵母饲料
4、QB/T 2074-1995 酿酒活性干酵母
5、QB/T 1501-1992 面包酵母
6、JUS E.M8.024-1987 面包酵母的活性的测定
酵母活性检测流程是怎样?
1、联系/咨询工程师,详细沟通了解检测需求;
2、工程师根据检测项目及检测需求进行报价;
3、双方确定签订合同及保密协议;
4、寄样/取样,开始检测;
5、完成检测,出具检测报告,进行后期服务;
如有相关检测需求欢迎通过在线咨询,微信咨询,拨打热线,预约检测留言等方式进行咨询,实验室工程师将会一对一为您详细解答。
最新发布
-
层析硅胶检测机构 层析硅胶指标检测
层析硅胶是一种以硅胶为主要原料的吸附分离材料。清析技术研究院可提供相关检测服务,可提供CMA/CNAS资质的检测报告,是...
查看详情 >
55
2026-05-20
-
碳氮共渗层检测中心 碳氮共渗层深度检测
碳氮共渗层是钢铁工件经碳氮共渗处理形成的表层,清析技术研究院可提供相关检测服务,可提供CMA/CNAS资质的检测报告,是...
查看详情 >
116
2026-05-18
-
生物炭基肥料检测中心 生物炭基肥料有机质检测
生物炭基肥料是以生物炭为主要材料的肥料,清析技术研究院可提供相关检测服务,可提供CMA/CNAS资质的检测报告,是专业的...
查看详情 >
276
2026-05-14

5887
